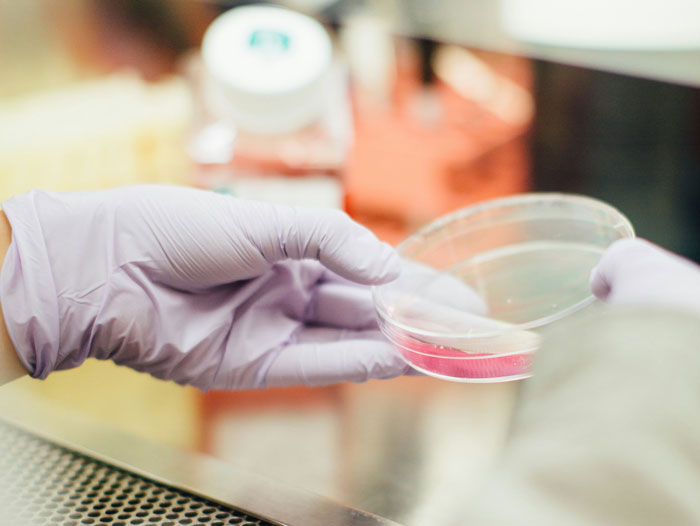

You know, some people have a real talent for destroying their own lives, as well as the lives of the people around them. Friends, relatives – in the end, their own family. We have told you similar stories more than once, now it’s time to tell you another one.
Our tale today was first published by the user u/PaternityThrowRA in the AITAH community on Reddit, and in less than 24 hours it has already received 22K upvotes and over 5.7K comments. A story about how inappropriate behavior deprived a guy of not only his marriage, but also his entire family. However, it’s quite possible that he himself didn’t want this family at all, who actually knows?
More info: Reddit
The author of the post has been married to her husband for 4 years and she gave birth to her first baby recently

Image credits: Asad Photo Maldives (not the actual photo)
The woman’s biological dad is Inuit, though she was raised in an adoptive family, but then reconnected with him


Image credits: u/PaternityThrowRA
The baby looked very much like his grandpa but had the dad’s eyes and nose

Image credits: Keira Burton (not the actual photo)



Image credits: u/PaternityThrowRA
The man, however, took the baby very coldly and demanded a paternity test
Image credits: Drew Hays (not the actual photo)

Image credits: u/PaternityThrowRA
Despite the test proved his paternity, the man dared to say that the wife’s bio dad could actually be her affair partner
So, the Original Poster (OP) is a new mom who recently gave birth to her first son after four years of marriage. The author of the post is mixed race (her biological dad is Inuit and her mom is white), while the woman’s husband is also white. An important note – it so happened that our heroine was raised by adoptive parents, but she also has reconnected with her biological paternal family.
The author says that she mainly took her appearance from her biological mom, but her son inherited many of the traits of his grandpa. However, the baby’s eyes and nose were exactly like his father’s. And so, when the OP’s husband saw the kid, he reacted very coldly, and even refused to take him in his arms.
Moreover, after some time, the husband decisively demanded a paternity test to make sure that he was the actual father of the child. The author was shocked by this demand, but gave in to the spouse’s pressure. As expected, the test showed that there was no betrayal, and that the father was the author’s husband.
What happened next should simply be included in the “Hall of Fame of the stupidest reasons for divorce” – if, of course, one is ever opened. Literally in the next few minutes the guy managed to:
- not express any apology to his wife for actually suspecting her of cheating;
- declare that “this guy you brought around – who knows, maybe it’s not your dad at all, but an affair partner?”;
- receive a powerful punchline in response – a reminder that two years ago he himself cheated on his wife, and she still forgave him;
- dub the wife a jerk for reminding him of this painful moment.
After this, do I need to clarify that the OP decided to stay in the nursery, and after that she packed her belongings, moved into the house with her adoptive parents, and is now collecting documents to file for divorce? It’s quite possible that this should have been done two years ago, after her husband’s betrayal, but, as they say, better late than never.

Image credits: Александр Велигура (not the actual photo)
Now let me fulfill the public order. The fact is that in the comments to the original post, one user wrote that it would be nice for journalists to conduct some research on the trend of men demanding a paternity test literally in the nursery, and in general, try to understand why they actually do this, thereby planting a grenade in their own relationships.
Okay, of course, people’s wishes are law to me. I can answer the second question immediately, without additional research, with the famous line from Jim Morrison’s song: “People are strange.” And people may have simply studied biology poorly at school and not know exactly how and what genes are transmitted through the male and female lines.
In addition, if the guy himself had experience of adultery, then it’s quite possible that he assumed a similar situation in relation to his wife. However, the trend itself of demanding paternity tests definitely exists nowadays. And here’s why.
“When selling fire extinguishers, start by talking about the fire.” This basic truth was uttered back in 1962 by David Ogilvy, one of the fathers of the modern advertising business. There is a DNA testing market, a market that has experienced a tendency of growth, but for that it was necessary to create the trend. And this is where marketing comes to the rescue.
If you google the phrase “30% of men are raising children that aren’t theirs,” you will get shocking results – a huge number of videos and posts dedicated to the same dubious statement, and practically no explanation of where these numbers come from. In fact, the answer is very simple.
Of course, according to the results of paternity tests, a certain proportion of men will still get an unpleasant result. And if we take statistics on the number of negative results of paternity tests and divide them by the total number of men who ordered this procedure, we get exactly about 30%. That is, not a third of the men on the planet are raising someone else’s bio children, but a third of those who have ordered a paternity test!
Isn’t it true that everything looks completely different now? But the so-called real non-paternity rate in the USA is much less scary. For example, the University of Chicago gives the following figures: 1.7% (if we exclude studies of unknown methodology) to 3.3% (if we include such studies). But 3.3 percent won’t give the desired sales volume. While 30% is just the opposite…
And now we return to our heroine’s husband, who de facto joined the sad row of other dads who destroyed their family with their own hands. More precisely, to commenters’ opinion about him. And this opinion is quite disappointing. “The utter disrespect your husband showed and continues to show is alarming,” one of the commenters simply wrote.
Other commenters are generally convinced that the divorce should have been filed two years ago, after the spouse’s infidelity. “Why on Earth did you have a baby with a man who cheated on you?” one of the people wrote in the comments. Where the actual [duck] do you guys find men like this?” another commenter reasonably questioned. So what do you, our dear readers, think about this whole story?
People in the comments criticized the husband harshly, praising the author for filing for divorce











